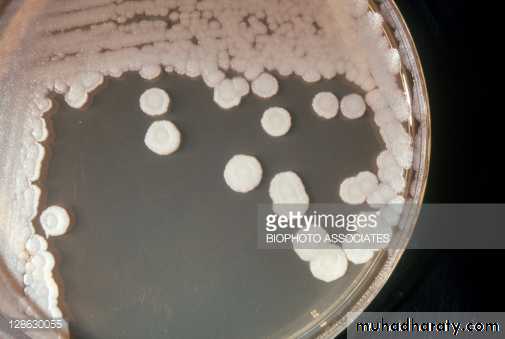
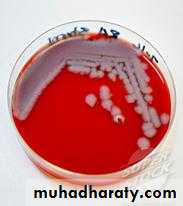
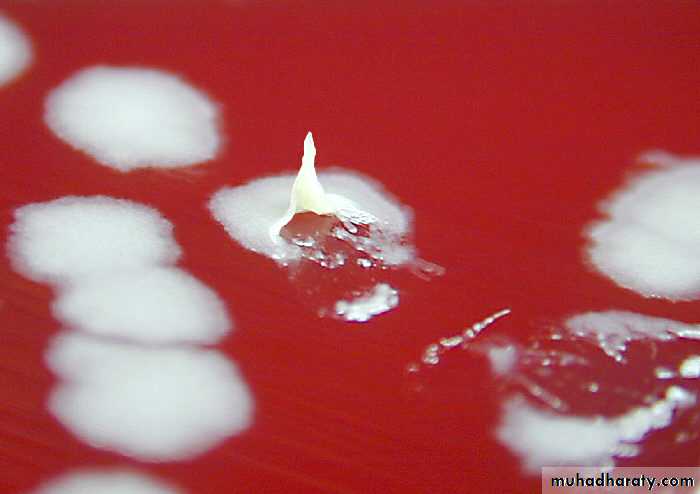
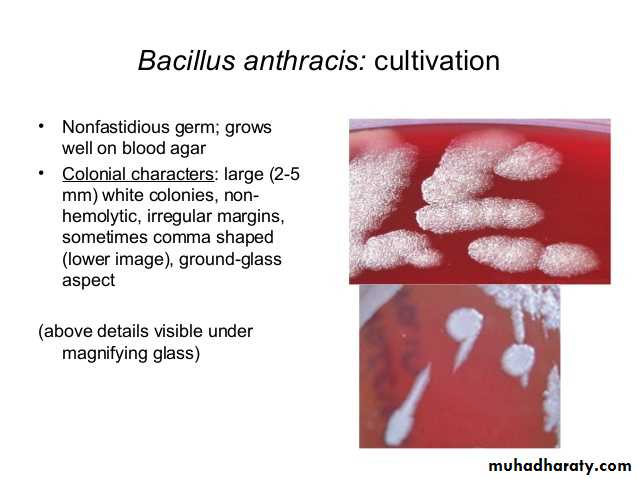
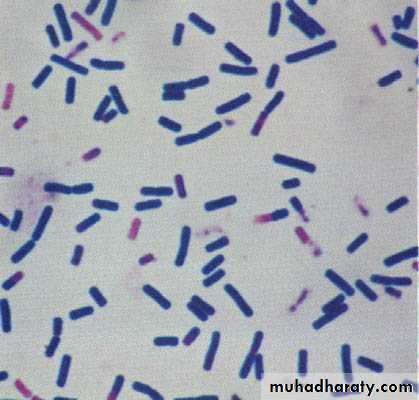
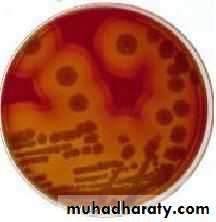
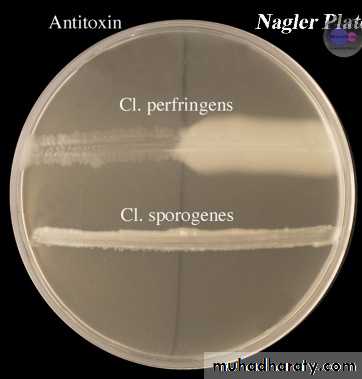
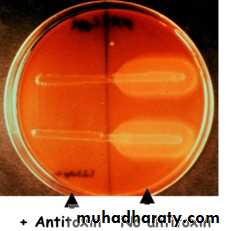
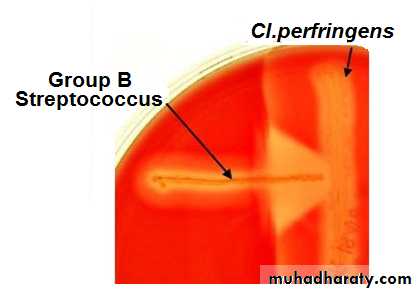
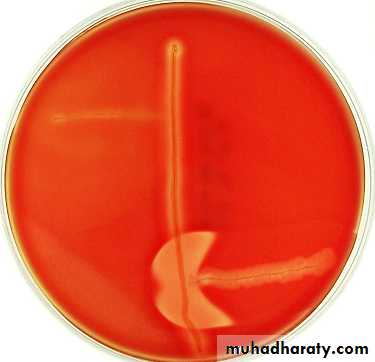
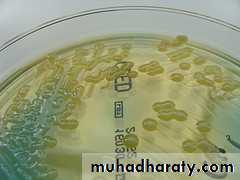

Bacillus , Clostridium &
ActinomycesMSc.Sarah Ahmed
Quest. Recognize anthracis VS cereus
There are 48 species included in the genus bacillus with the following general characteristics:1. Gram-positive bacilli
2. Spore former3. Aerobic and facultative anaerobic
THE MOST IMPORTANT PATHOGENS:
1. Bacillus anthracis2. Bacillus cereus
3
BACILLUS ANTHRACIS
4
Morphology:
1. Large gram positive bacilli.2. Non-motile.
3. Found singly, in pairs or in long chains.
4. Capsule could be demonstrated during growth in infected animals.
5. Spores are formed in culture, dead animal's tissue but not in the blood of infected animals.
6. Spores are oval and centrally located.
Survival in Soil
• Spores remain viable in soil for decades.
• In World War II in Scotland spores were exploded.
• Survived for >40 years and were eradicated in 1987
• Changing environmental conditions (temp. rain etc.) help in survival and multiplication.
5
6
Gram stain of Bacillus anthracis showing Gram-positive rods forming long filaments. “Bamboo –like appearance”
7
showing endospores as green and the vegetative cell as red
Cultural Characteristics:= Blood Agar and Nutrient Agar are commonly used to cultivate the bacilli.
Plates are incubated aerobically at 37 oC.
= On blood agar plates, colonies have irregular borders and are non-hemolytic.
= On nutrient agar: They are described as "Coma shapped".
8
9
Colonial growth of Bacillus anthracis. When lifted by an inoculation loop, colonies, in this case on sheep blood agar, show a tenacity that allows them to be pulled up and stay upright with a texture similar to egg whites.
= Biochemical Identification:
2. Gelatine liqefaction test: Negative after 7 days. Growth3. Nitrate reduction test: Positive
4. Starch hydrolysis test: Positive
5. Voges-Proskauer test: Positive
6. Sensitivity to penicillin. Sensitive
10
11
Clostridium
The genus consists of G+ve ,anaerobic, Sporeforming bacilli.
12
SPORES
The shape & position of spores varies in different spp. & thus useful in their identification. Spores may be;Central or equatorial in Cl.bifermentans(Spindle shaped)
Sub terminal in Cl.perfringens
Oval or terminal in Cl.tertium(resembling tennis racket)
Spherical and terminal in C.tetani( drum sticks )
13
1.Clostridium perfringens(Cl.welchii)
Morphology-Large Gram-positive bacilli with straight, parallel sides & slightly rounded ends.
-Measure 4-6x1μm in size,occuring singly or in chains
-Pleomorphic,capsulated & non-motile.
-Spores are central or sub terminal. Spores are rarely seen in culture media or material from pathogenic lesions, a characteristic morphologic feature
14
CULTURAL CHARACTERISTICS
-Robertson’s cooked meat broth is ideal; meat is turned pink but not digested with sour odor.-Stormy fermentation of lactose in litmus milk; the acid coagulates casein-acid clot.
-On BAM: Target haemolysis
BIOCHEMICAL REACTIONS:
Glucose Indole -ve
Lactose Fermented with MR +ve
Maltose A & G production VP -ve
-H2S prodn. test & Nitrate redn. test - +ve
15
Left to right:
• RCM: Meat turned pink but not digested• Litmus Milk: Stormy fermentation & acid clot in Litmus milk
• BAM: Target hemolysis
16
4.Nagler’s Reaction
-Rapid detection of Cl.perfringens from clinical sample-Done to detect the lecithinase activity of alpha toxin
-Characteristics opalescence is produced around colonies in +ve test due to breakdown of lipoprotein complex in the medium
17
5.Reverse CAMP Test:
-Used for differentiation of Cl.perfringens from other clostridium species.-CAMP +ve Group B Streptococcus is streaked in SBA & Cl.perfringens is streaked perpendicular to it “arrowhead”(enhanced) hemolysis is seen between growth of Cl.perfringens & Group B streptococcus
18
Anaerobic, filamentous, gram positive bacillus
Exhibit true branchingThought by early microbiologist to be fungi because of:
Morphology
Disease they cause
ACTINOMYCES
Actinomyces species grow well in enriched media with brain-heart infusion and may be aided in growth by an atmosphere of 6-10% ambient carbon dioxide. They grow best at 37°C. Colonies can appear at 3-7 days, but, to ensure that no growth is missed, observe cultures for 21 days.
Culturing of Actinomyces
Dr.T.V.Rao MD
20Diagnosis:
.
Gram stain.
Culture. (poor growth in culture only in less than 50% of cases.) Sulphur granules (yellowish myecelial masses)
Observe for Gram positive branching filaments
Dr.T.V.Rao MD
21Examination of drained fluid under a microscope shows "sulphur granules" in the fluid. They are yellowish granules made of clumped organisms
Examination of discharges will help in diagnosis
Dr.T.V.Rao MD
22sulphur granules
24